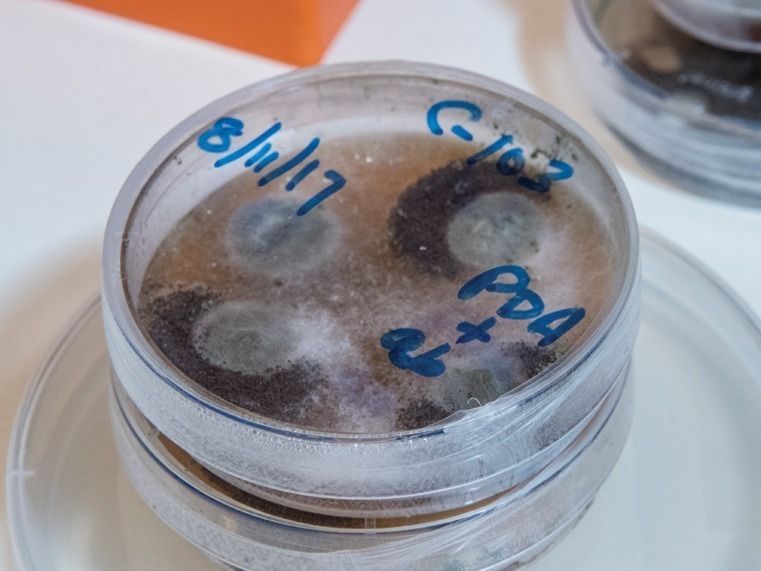

Newly discovered molecules that could prove to be anti-cancer agents.
Plant-derived compounds that could give us new ammunition against deadly drug-resistant bacteria such as MRSA.
Nanoparticles that might one day help doctors focus cancer drugs more precisely on tumors.
New drug candidates to minimize damage to the brain after a stroke.
That’s a small sample of the research that UNCG’s Medicinal Chemistry Collaborative — MC2 — is carrying out.
And there’s certainly more where that came from. That’s what happens when you combine a couple dozen chemists, biochemists, biologists, and other scientists, plus their labs, students, and millions of dollars in research grants, together in a single center.
MC2 has been around, under different names, for about 10 years. But the new name is part of an effort to draw in a wider array of researchers and provide the UNCG scientists involved with more chances to learn from one another.
“The goal is to support each other, and to train students, and to engage with the greater scientific community and the community in general,” says Professor Nadja Cech, who, along with Professor Nick Oberlies, is co-director of MC2.
Sometimes that means one researcher saying something or sharing a story that sparks a new idea. Sometimes it means opportunities to collaborate and combine knowledge or access to special resources. Sometimes it means another colleague to ask for advice or finding the perfect mentor.
It certainly means high-impact research.

Oberlies (above) and his collaborators hope to identify next-gen drugs in natural products. “Fungi are the second most diverse organisms on the planet,” he explains. There are millions of unidentified fungal species — each one a treasure trove of unidentified compounds with the potential to improve health and save lives. See more photos on UNCG Research Flickr.
A numbers game
Dr. Oberlies and his students have spent a lot of time wading through streams and ponds in parks around North Carolina, collecting fungi. They take them back to the lab, grow and analyze them, and start looking for new molecules that might have therapeutic or other practical applications.
“Fungi are the second most diverse organisms on the planet,” Oberlies says. Scientists estimate there are millions of species, but only about 120,000 have been named. In fact, Oberlies and his team frequently find new species; recently they discovered a whole new order of fungi.
In the last decade, Oberlies says, his lab has collected and analyzed thousands of fungal species, isolated and determined the structures of hundreds of new compounds from those fungi, and then tested those using biological assays to see which might have medicinal value.
He’s also able to tap the expertise and resources of another professor, Cedric Pearce, an adjunct faculty member and CEO of Hillsborough-based biotech company Mycosynthetix Inc. That company maintains a library of over 55,000 fungal species collected from around the world.
“Mycosynthetix pioneered the miniaturized high-throughput approach to culturing fungi and has spent the past 16 years providing access to this valuable resource to drug discovery groups,” Pearce says. “The chance of finding new molecules from our fungi is therefore high, and by using the historical data we can quickly find active compounds.”
Oberlies says the knowledge and expertise that Mycosythentix brings to the lab bench have been invaluable.
“We went through 4,000 fungi, we isolated 400 compounds and we’ve got four promising leads,” he says. “It’s a bit of a numbers game.”
Those four leads? Three have the potential to be used against cancer, and the fourth shows promise against MRSA — methicillin-resistant Staphylococcus aureus, the dangerous staph infection plaguing healthcare facilities worldwide.
Oberlies’ team has tested the compounds in his lab, in test tubes, and now they’re moving into in vivo trials at other research labs, where scientists will see if they work in a living organism.
Natural synergies
MRSA and other bacterial infections were also a target for a five-year investigation into how goldenseal, an herbal supplement, kills bacteria.
Unlike traditional drugs, where a single compound does all the heavy lifting, plant-based products often have many molecules working together, says Dr. Cech, whose research focuses on medicinal plants.
“We have found multiple compounds in that same plant that target bacteria in different ways and that work together synergistically,” she says. “We’re seeing that you get a different result when you treat an infection with goldenseal extract from the plant, or a tea from the plant, than you would get if you took just one of the isolated compounds from it.”
Cech is an analytical chemist by training — an expert at breaking down something into its constituent parts and figuring out what those parts are. The goldenseal research taps those analytical strengths. “We can say which compounds are working in what way, and how they collectively do a better job of wiping out bacteria.”



Above, Cech and research scientist Huzefa Raja lead a team of graduate and undergraduate students on a sample-collecting trip.
In 2016, Cech won an $800,000 National Institutes of Health predoctoral training grant to support graduate students working in natural products. This year, she received the UNCG Undergraduate Research Mentor Award. Of the 50 undergraduates she has mentored, 60 percent have gone on to graduate programs or professional programs. See more photos on UNCG Research Flickr.
Lighting the Way
Dr. Sherri McFarland, who joined the Department of Chemistry & Biochemistry a year ago, is focused on photodynamic therapy, using light energy to activate or strengthen therapeutic compounds in the body.
She and her partners have founded a company — Photodynamic Inc. — based on light-responsive natural products that can eliminate oral biofilms, which are associated with cavities and gum disease. They’ve also licensed a light-responsive bladder cancer drug to another company; that treatment is now in human trials.
For her work at UNCG, the professor is turning her attention to nanophoto medicine.
One of the challenges with some photodynamic applications, she says, is that not all wavelengths of light are equally effective. Sometimes, the frequencies that penetrate tissues the best don’t carry enough energy to activate light-sensitive, therapeutic compounds to attack cancers.
But some types of nanoparticles — very tiny particles with specific chemical structures — can “up-convert” the light, absorbing a lower-energy photon and then emitting a high-energy photon. That new, high-energy light has enough energy to activate the therapeutic compound.
“The idea is we could then treat larger tumor volumes,” McFarland says. By combining light-therapeutic compounds with these nanoparticles, doctors could potentially treat tissues deeper in the body, where longer-wavelength light can penetrate and then be converted to shorter wavelengths to activate the drug.
“You start out with a lot of different combinations of individual molecules and nanoparticles and then you whittle those down to the top performing, according to whatever screening procedure you’re using,” McFarland says.
Combinations that work successfully in the lab will go on to further testing. They could also form the basis of new companies that could be spun out of McFarland’s lab.

McFarland and her collaborators have developed a light-responsive bladder cancer drug that is now in human clinical trials with Theralase Technologies. They’re also collaborating with the company to develop drugs to treat glioblastoma, a type of brain cancer.
Life experiences spark collaborative reactions
You might say that Cech and Oberlies are connected to their purpose by the Pacific yew tree.
Cech grew up on a farm in Oregon where she learned about the local plants and their traditional medicinal uses. One of the trees on her family farm was the yew, long used in traditional medicine.
Cech skipped high school, starting at Oregon’s Rogue Community College when she was 14. A science professor there introduced her to chemistry. He would take Cech and her classmates on field trips to remote lakes and streams to test water quality.
“For me, chemistry was always a very hands-on thing, and the link between chemistry and the natural world was always very obvious,” she says. “I actually thought I might pursue botany when I first went to college because I loved plants so much, but then realized that I really loved how chemistry makes order out of the world.”
That love of chemistry persisted through graduate school — including a stint doing mass spectrometry in a windowless concrete building in New Mexico. Then, she came to UNCG in 2001 and started doing research on plants.
“I was just absolutely enthralled,” she says. Cech knew she wanted to conduct research on natural products, but despite her analytical chemistry bona fides and childhood knowledge of plants, she had no formal training in the chemistry or analysis of plants.
She needed someone who knew about natural products and chemistry, which led her to Oberlies, who ran the Natural Products Laboratory at the Research Triangle Institute in Research Triangle Park, N.C.
Oberlies learned about the yew tree a different way, from mentor scientists at Research Triangle Institute, Dr. Mansukh Wani and the late Dr. Monroe Wall. Those scientists are known around the world because they derived Taxol, an important cancer drug, from the bark of the Pacific yew.
Oberlies has traveled all over the world with Wani, listening to him speak to groups. Audience members sometimes weep during his talks, and afterward come to speak to him.
“They’ll say things like ‘My mother passed away from cancer, but she had five extra years because of Taxol,’” Oberlies says. “I’ve seen that happen more times than I can count.”
In 2009, he joined Cech at UNCG.
It’s been a fruitful partnership. One of their latest endeavors is the NIH Center of Excellence for Natural Product Drug Interaction Research, a $10 million collaboration with Washington State University and the University of Washington. UNCG is the analytical lead on the project, which is examining how the body’s metabolism of natural products can impact the effects of modern medicines.
For Oberlies, who has always seen science as a process of discovery, this is the idea that animates his work: To find something that makes a difference.
“I just want to do something that positively affects humanity,” he says. “You’re doing it because you want to have an impact on society.”
In July, Cech and Oberlies became inaugural recipients of Patricia A. Sullivan Distinguished Professorships in the Sciences.
Scalable synthesis
In drug development, finding a compound that might have therapeutic properties is only half the battle. Researchers must still be able to make enough of the substance to test it. And if it ends up being approved for use in humans, drug makers must also figure out how to produce large quantities of it.
That’s one of the things that Mitch Croatt, associate professor of organic chemistry and the head of the Department of Chemistry & Biochemistry, does.
“We make molecules,” he says. “The approach that guides us is to try to make compounds in as few steps as possible. This reduces the time, waste, and cost of a synthesis.”
For one project, Dr. Croatt created a new process — nine steps instead of 15 — to synthesize isocarbacyclin analogues, starting with simple, inexpensive materials. Collaborators at the Stanford University School of Medicine are testing them. Early results suggest they could minimize brain damage after a stroke.
Croatt says one of the most valuable aspects of MC2 is the synergy created by the interaction among the scientists.
“By talking and sharing research results, we can help one another by either directly collaborating or simply giving advice,” he says. Six of his last eight published papers were collaborations with other MC2 members.
For example, he’s working with Cech and Oberlies to isolate compounds from fungi that may have anti-cancer effects, and then optimize the structure of those molecules. Science, Oberlies notes, “is all about teamwork.”
That teamwork extends far beyond the relationships among faculty.



“Our nickname, MC2, alludes to Einstein’s famous equation,” says Cech. “It reflects the energy created by our collaboration.” Students are an essential part of that formula.
Above, from left to right: McFarland with graduate researcher Derick Jones. Former undergraduate and current postbaccalaureate researcher Michael Brandon Schroder Spano with Croatt and undergraduate researchers Mark Perez and Jarrod Stanley. Undergraduate researcher Ann Marie Lee with Oberlies and undergraduate researcher Tatiana Hines. See more photos on UNCG Research Flickr.
Next generation scientists
UNCG faculty take their responsibilities to teach students and mentor future scientists seriously.
Derick Jones, a doctoral student in medicinal biochemistry, works in the McFarland lab. One of his primary duties is to work with cancer cell lines. He grows the cancer cells that are used to test drug candidate compounds in test tubes. Then he observes the way light interacts with the compounds to (hopefully) kill those cancer cells.
“We have state of the art instruments and technology that are extremely novel in the science community,” Jones says. “I am excited to delve into uncharted territory within the photodynamic therapy field.”
Beyond the opportunity to do cutting edge research, Jones says, the mentorship from McFarland is also invaluable.
“I feel like one of the most fortunate people alive to be working with her,” he says. “She has pushed me past what I had considered being my best.”
MC2 faculty also work closely with undergraduates. Biochemistry major Luis Mejia Cruz has been working in Cech’s lab to better understand how certain compounds combat MRSA.
“I was involved in all of the processes, from simple lab techniques such as sample preparation, to culturing the strains of bacteria, to running the bioassays and screening them using analytical instruments such as high-performance liquid chromatography and mass spectrometry systems, as well as processing the data,” he says.
Mejia Cruz plans to pursue a master’s degree in chemistry and one day work as a researcher, perhaps in medicinal chemistry.
Cech finds great satisfaction in having the same kind of impact on students that her first college chemistry professor had on her. Grant funding won by the center does more than support research, she explains. It supports students — and sometimes changes their lives.
“They’re getting into the lab and finding out that chemistry is something they didn’t expect at all,” she says. “They’re going off to careers as research scientists. That’s what having funded research does.”